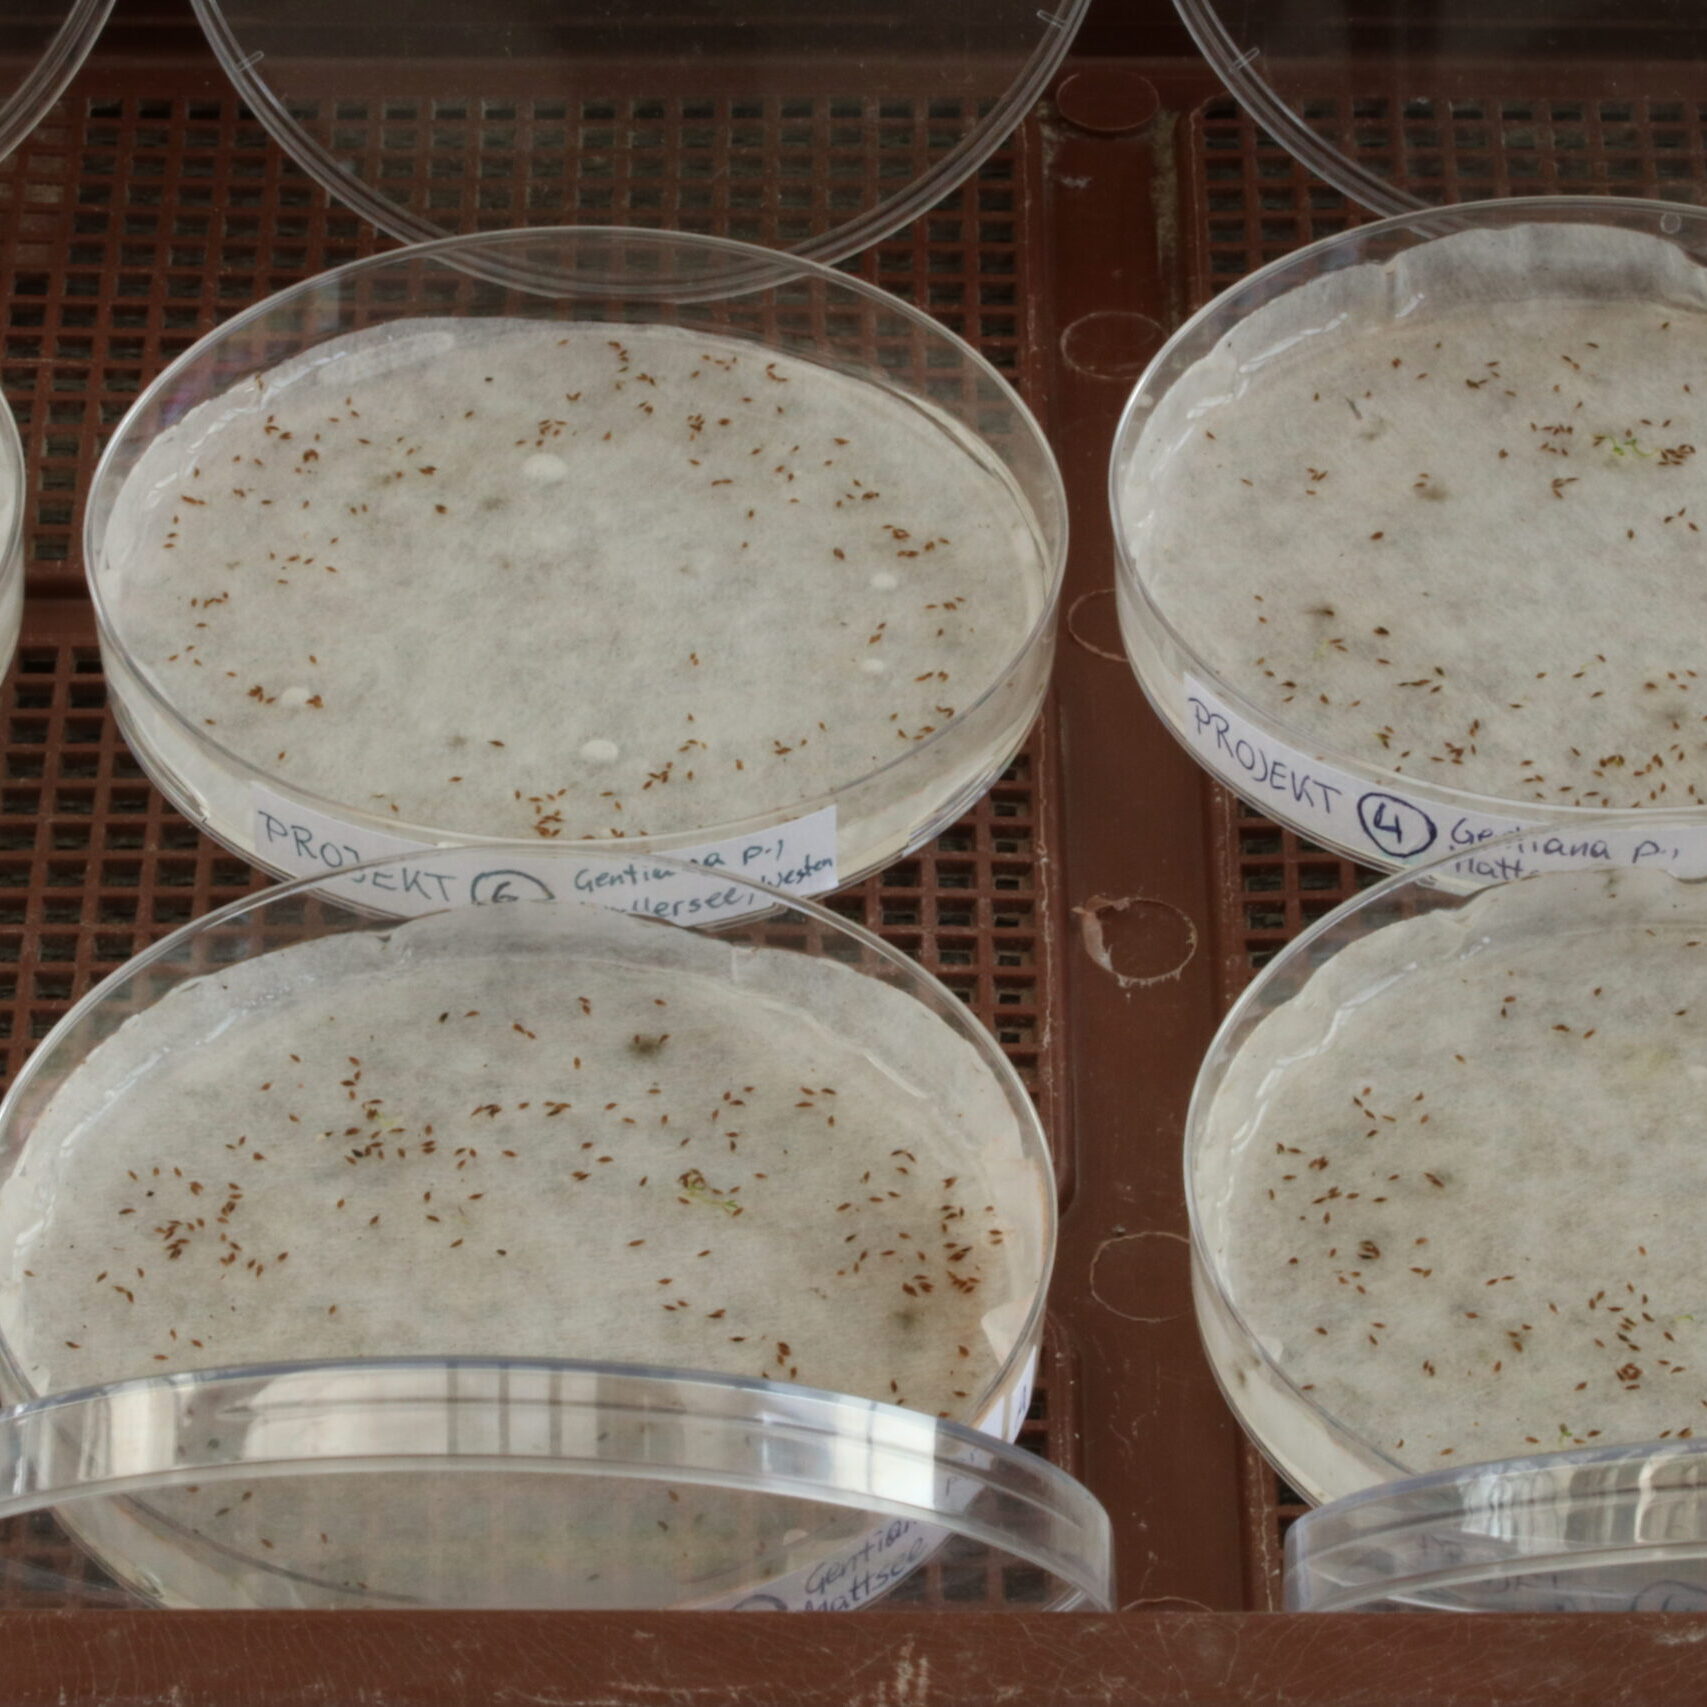

Gefährdete Pflanzenarten Österreichs: Vermehrung und Wiederansiedelung durch Botanische Gärten
Der Verlust der Biodiversität bedroht unsere Ökosysteme auf vielfältige Weise. Nicht zuletzt schrumpfen die Populationen vieler heimischer Pflanzenarten in einem bedenklichen Ausmaß. Um diesem seit Jahren fortlaufenden negativen Trend entgegenzuwirken, setzen Botanische Gärten in Österreich in einem durch den Biodiversitätsfonds finanzierten Projekt umfangreiche und nachhaltige Schutz- und Erhaltungsmaßnahmen für mehr als 50 ausgewählte gefährdete Pflanzenarten um.
Im Artenschutzprojekt Botanische Gärten arbeiten die Botanischen Gärten der Universität Innsbruck, des Landesmuseums für Kärnten, der Paris Lodron Universität Salzburg, der Universität für Bodenkultur Wien und der Universität Wien zusammen. Die gefährdeten Pflanzenarten wurden anhand der aktualisierten „Rote Liste für Farn- und Blütenpflanzen Österreichs 2022“ (RL Ö) ausgewählt. Nach der Sammlung von Saatgut erfolgt die Wiederansiedlung durch Aussaat oder Auspflanzung von Jungpflanzen in ausgewählten Habitaten. Die Aufwertung dieser Flächen durch Pflegemaßnahmen spielt dabei eine wichtige Rolle. Ein begleitendes Monitoring dokumentiert die Etablierung der Pflanzen.
Der Austausch von Erfahrungen und die Stärkung von Synergien werden durch regelmäßige Treffen in den Botanischen Gärten gefördert. Informationen zu den Pflanzenarten und ihrer Kultivierung werden in der Datenbank der Erhaltungskulturen des Verbandes Botanischer Gärten erfasst. Interessierten Bürgerinnen und Bürgern werden die gewonnenen Erkenntnisse im Rahmen von Führungen und Ausstellungen in den Botanischen Gärten vorgestellt. Über die sozialen Medien informieren die Botanischen Gärten über Aktuelles zum Projekt.
Sammeln – Vermehren – Wiederansiedeln – Dokumentieren
Sammeln
Vermehren
Weitere Bilder
Projektpartner

Der Botanische Garten der Universität Salzburg widmet sich im Rahmen des Artenschutzprojekts der Kultivierung von Arten, die für den Lebensraumtyp der Pfeifengraswiesen charakteristisch sind. Diese Wiesen gedeihen auf kalkreichen, torfigen und tonig-schluffigen Böden (Molinion caeruleae).
Durch die Kooperation mit dem Haus der Natur in Salzburg können aktuelle Standorte der gefährdeten Pflanzenarten abgefragt werden. Die Aussaat oder die Auspflanzung von Jungpflanzen wird zusammen mit der Biotopschutzgruppe HALM in ausgewählten Habitaten im Bundesland Salzburg durchgeführt.
Im Botanischen Garten Salzburg arbeiten wir mit folgenden Arten
Informationen zu allen Arten finden Sie auf der Webseite des Botanischen Gartens der Universität Wien
Feuchtwiesen-Pracht-Nelke Dianthus superbus subsp. superbus – Caryophyllaceae

Die Feuchtwiesen-Pracht-Nelke wächst auf mageren Streuwiesen und in Flachmooren.
Aussehen und Standortansprüche
Die Feuchtwiesen-Pracht-Nelke ist eine krautige, mehrjährige Pflanze mit überwinternden, kriechenden Langtrieben und schlanken Blühtrieben, die 20 bis 60 cm hoch werden. Auffällige, lila- bis hellpurpurne Blüten erscheinen einzeln oder zu wenigen im Zeitraum von Juni bis Juli, wobei eine zweite Blüte im September möglich ist. Die Blüten duften stark, ihre Kronblätter sind mehrfach fransig zerschlitzt. Die Feuchtwiesen-Pracht-Nelke kommt auf Pfeifengraswiesen und auf wechselfeuchtem oder nassem, sumpfigem Moorboden vor.
Verbreitung
In Österreich kommt die Feuchtwiesen-Pracht-Nelke im Gegensatz zur Alpen-Pracht-Nelke (D. superbus subsp. alpestris) in den Feuchtwiesen in hügeligem Gelände und der unteren montanen Stufe vor – im Wiener Becken, im südlichen Burgenland, im Salzburger Land. Die vorhandenen Populationen sind stark voneinander isoliert und werden zunehmend kleiner, wobei stabile Bestände nur bei traditioneller Mähwirtschaft erhalten werden könnenie vorhandenen Populationen sind stark voneinander isoliert und werden zunehmend kleiner, wobei stabile Bestände nur bei traditioneller Mähwirtschaft erhalten werden können.
Gefährdung und Schutz
Die Rote Liste Österreichs stuft die Art als stark gefährdet („Endangered“) ein. Primäre Gefährdungsursache ist der Lebensraumverlust durch die Nutzungsaufgabe magerer Feuchtwiesen. Ein Erhalt der Populationen ist durch Aufrechterhaltung traditioneller Wirtschaftsformen (späte Mahd) möglich. Durch die Nutzung und Kultivierung als Zierpflanze und unerwünschte Aussaat und Auspflanzung gebietsfremder Pracht-Nelken-Pflanzen an geeigneten Standorten wird die genetische Vielfalt heimischer Populationen gefährdet.
Besonderheiten
Der Gattungsname Dianthus geht auf das altgriechische Wort dios für Gott und anthos für Blüte zurück. Die Blüten dieser „göttlichen Blume“ verströmen einen angenehmen, süßen Duft, der besonders in den Abendstunden intensiv ist. Dies macht sie attraktiv für Bestäuber wie Schmetterlinge und Nachtfalter und zu einer beliebten Gartenpflanze.
Lungen-Enzian Gentiana pneumonanthe – Gentianaceae

Der Lungen-Enzian ist stark im Rückgang begriffen – und mit ihm eine Schmetterlingsart, deren Raupen sich von den jungen Blütenknospen ernähren.
Aussehen und Standortansprüche
Der Lungen-Enzian ist eine krautige, mehrjährige Staude, die 15 bis 40 cm hoch werden kann. An dem unverzweigten Blütenstand sitzen glockenförmige tiefblaue Blüten, mit grün bis weiß punktierten Streifen, die von Juni bis September erscheinen. Die Art kommt auf sehr mageren Feuchtwiesen (Pfeifengraswiesen, Borstgrasrasen), in Flachmooren und auf feuchten Heiden vor. Oftmals sind an ein und derselben Pflanze Blüten und Samen gleichzeitig vorhanden.
Verbreitung
Die eurasische Verbreitung der Art von Nordspanien und dem nördlichen Balkangebirge im Süden bis ins südliche Skandinavien beschränkt sich in Österreich auf vier stark voneinander isolierte Teilareale: im südlichen Wiener Becken, im Südosten der Steiermark, sowie in den mittleren Gebirgsstufen in Kärnten und rund um Salzburg.
Gefährdung und Schutz
In der Roten Liste Österreichs wird der Lungen-Enzian aufgrund des starken Rückgangs der Pfeifengraswiesen als stark gefährdet („Endangered“) eingestuft. Es gibt nur noch wenige Bestände in Österreich. Die primäre Gefährdungsursache ist der Lebensraumverlust durch Entwässerung und Düngung feuchter Wiesen, durch ungünstige Mahd-Zeitpunkte sowie Nutzungsaufgabe und Verbuschung von ertragsarmem Grünland. Das Saatgut des Lungen-Enzians wird im Botanischen Garten zur Keimung gebracht und Jungpflanzen werden auf den Wiederansiedelungsflächen ausgepflanzt.
Besonderheiten
Der Lungen-Enzian ist ein Flachland-Enzian, der früher häufig auf Pfeifengraswiesen zu finden war. Einst diente er als Heilmittel bei Lungenkrankheiten, daher der Trivialname „Lungen-Enzian“. Die Raupen des Lungenenzian-Ameisenbläulings (Phengaris alcon) ernähren sich von den jungen Blüten des Lungen-Enzians. Vor dem Verpuppen locken sie mit ihrem Honigtau bestimmte Ameisenarten an. Diese Tragen die Raupen in ihren Bau, wo sie vorübergehend als Parasiten leben. Die enge Verbindung zwischen Enzian, Schmetterling und Ameisen ist ein Beispiel für die Komplexität der biologischen Vielfalt auf der Erde.
Sumpf-Gladiole Gladiolus palustris – Iridaceae

Der Name der Sumpf-Siegwurz leitet sich aus dem Aberglauben ab, dass der Besitz der Pflanze unbesiegbar macht. Erst nach fünf Jahren in Kultur ist die Knolle groß genug, um ausgepflanzt zu werden.
Aussehen und Standortansprüche
Die Sumpf-Siegwurz oder auch Sumpf-Gladiole ist eine mehrjährige Staude mit kräftigem unterirdischem Rhizom, in das sie sich in den Wintermonaten komplett zurückzieht (Geophyt). Die Pflanze bildet pro Rhizom-Abschnitt mehrere schmale schwertförmige Grundblätter und einen bis zu 60 cm hohen Blütenstand mit 2 bis 6 großen karminroten Blüten, die in Ähren angeordnet sind. Während ihrer Blütezeit, von Mitte Juni bis Juli und im Spätsommer, wird sie von langrüsseligen Hummeln bestäubt. Die Pflanzen blühen meist ab einem Alter von 3 bis 5 Jahren. Die bis zu 0,5 cm großen Samen sind glänzend rostbraun und geflügelt. Die Art kommt einerseits auf sehr mageren Feuchtwiesen (Pfeifengraswiesen), aber auch auf trockenen Kalkmagerrasen und in trockenen, lichten Kiefernwäldern vor.
Verbreitung
Die Sumpf-Siegwurz kommt ausschließlich in Europa vor: von Frankreich bis in den Balkan und die Baltischen Länder, schwerpunktmäßig nur im Umland der Alpen, der Karpaten und der deutschen Mittelgebirge. In Österreich kommt sie nur an wenigen Stellen im Wiener Becken und im Untersberg-Vorland (Land Salzburg) vor.
Gefährdung und Schutz
In der Roten Liste Österreichs wird die Art als stark gefährdet („Endangered“) eingestuft. Pflücken und Ausgraben dieser Art ist laut Naturschutzgesetz verboten. Hauptgefährdung ist der Lebensraumverlust durch Nährstoffeinträge. Weitere Gefährdungsursachen sind ungünstige Mahd-Zeitpunkte sowie die Aufgabe der Nutzung und das Zuwachsen von wenig ertragreichen Grünlandflächen. Auch direkte Schäden durch Menschen wie Pflücken, Ausgraben und Trittbelastung gefährden den Fortbestand. Durch die zeitgerechte Mahd Ende Juli bis Anfang August könnten die noch existierenden Bestände geschützt werden.
Besonderheiten
Die Knolle der Pflanze ist in ein Fasernetz eingeschlossen, das an ein Kettenhemd erinnert. Im Mittelalter glaubte man, dass derjenige, der die Knolle unter der Rüstung trägt, im Kampf unverwundbar und vor bösen Geistern geschützt sei. Der Trivialname „Siegwurz“ weist noch auf diesen Glauben hin. Trotz ihrer Attraktivität ist die Kultivierung der Sumpf-Siegwurz anspruchsvoll, und statt Wildformen werden im Garten Kultur-Sorten eingesetzt.
Klebriger Lein Linum viscosum – Linaceae

Der Klebrige Lein mit seinen großen rosaroten Blüten mit auffallend dunkler Aderung. Von den neun in Österreich vorkommenden Lein-Arten besitzt nur der Klebrige Lein leuchtend rosa Blüten, die schon aus der Ferne gut zu erkennen sind.
Aussehen und Standortansprüche
Der Klebrige Lein ist eine krautige, mehrjährige Art, die zwischen 30 und 50 cm hoch wächst. Die ältesten gefunden Exemplare der Art waren 9 Jahre alt. Der Stängel ist mit abstehenden Drüsenhaaren versehen, die den Stängel klebrig erscheinen lassen. Die mit 3,5 bis 5 cm Durchmesser vergleichweise großen rosaroten Blüten besitzen eine dunkle Aderung und erscheinen von Mai bis Juli. Die Art wächst auf frischen bis mäßig trockenen, kalkreichen Böden, bevorzugt offene Standorte und ist auf Kalkmagerrasen zu finden.
Verbreitung
Der Klebrige Lein kommt von Nordspanien bis Slowenien vor, nördlich der Alpen reichen seine Vorkommen vom bayerischen Alpenvorland bis südlich der Donau. In Österreich gibt es Vorkommen in Oberösterreich, Salzburg, Kärnten und Tirol, in der Schweiz fehlt die Art gänzlich.
Gefährdung und Schutz
Der Klebrige Lein ist eine durch Lebensraumverlust und ungünstige Standortbedingungen bedrohte Art, welche in der Roten Liste Österreichs als gefährdet („Vulnerable“) eingestuft wird und in den westlichen Teilen der Nordalpen als stark gefährdet („Endangered“) gilt. Die ursprünglichen Vorkommen des Klebrigen Leins sind vielerorts verschwunden, da er infolge der Aufgabe der Mahd und einsetzender Verbrachung von konkurrierender Vegetation verdrängt oder durch aufkommende Gehölze verschattet wird. Die Art reagiert sehr empfindlich auf Beweidung, eine späte Mahd wäre optimal, doch eine entsprechende Bewirtschaftung ist oft nicht gegeben.
Besonderheiten
In den leuchtend rosa Blüten entwickeln sich bis zu zehn glatte, hellbraune Samen, die erst spät im Jahr reifen. Pro Pflanze können bis zu 500 Samen geerntet werden. Besonders auffällig ist die Vielfalt der Laubblätter: Von zarten hellgrünen bis hin zu derben wachsartigen dunkelgrünen Laubblättern finden sich viele Formen.
Knäuel-Glockenblume Campanula glomerata – Campanulaceae

Die Knäuel-Glockenblume beeindruckt mit ihrer intensiven Farbe und ist ein wertvoller Indikator für die Artenvielfalt in extensiven Halbtrockenrasen. Sie ist eine der auffälligsten und farbintensiven Blumen in extensiv genutzten Halbtrockenrasen und ein sensibler Indikator der Artenvielfalt solcher Standorte. Häufige und zu frühe Mahd führt zu massivem Rückgang der Art.
Aussehen und Standortansprüche
Die Knäuel-Glockenblume ist eine mehrjährige Staude, die 30 bis 60 cm hoch werden kann. An der Spitze des Stängels sitzen die blauvioletten Blüten in endständigen Köpfen. Die Blätter sind am Grunde gestielt und zum Blütenkopf hin am Stängel anliegend. Die Knäuel-Glockenblume blüht spät im Jahr, von Juni bis September, und wächst auf sommerwarmen, mäßig frischen bis trockenen Wiesen, vorzugsweise auf lehmigen, kalkreichen Böden.
Verbreitung
In Österreich kommt die Knäuel-Glockenblume noch vergleichsweise häufig vor, vom Wiener Becken bis in die mittlere montane Stufe in den Alpen. Sie wächst an Randsäumen magerer Wiesen an Wald- und Wegrändern. In vielen Teilen des Landes sind die Populationen jedoch stark voneinander isoliert und werden zunehmend kleiner. Außerdem ist die Knäuel-Glockenblume durch hohe genetische Variabilität innerhalb der Art charakterisiert, wobei einige Unterarten und Varietäten lokal begrenzt und daher besonders gefährdet sind.
Gefährdung und Schutz
In der Rote Liste Österreichs ist die Knäuel-Glockenblume als gefährdet („Vulnerable“) eingestuft. Primäre Gefährdungsursache ist der Lebensraumverlust durch zu frühe Mahd, Eutrophierung und Nutzungsaufgabe trockener Wiesen. Würden Randsäume später gemäht, könnte diese spät blühende Art sich noch aussamen und auf natürliche Weise vermehren.
Besonderheiten
In der norwegischen Flora wird die Knäuel-Glockenblume als nicht-heimische Pflanze mit Invasionspotential gelistet. Als pflegeleichte Gartenstaude ist die Knäuel-Glockenblume sehr beliebt, unter den vielen Kulturformen gibt es auch weißblütige Formen wie Campanula glomerata ‘Alba‘.
Sibirische Schwertlilie Iris sibirica – Iridaceae

Die Sibirische Schwertlilie wächst auf Nass- und Sumpfwiesen, die zunehmend aus der Landschaft verschwinden.
Aussehen und Standortansprüche
Die Sibirische Schwertlilie ist eine mehrjährige Staude, die bis zu 80 cm hoch werden kann. Die äußeren Blütenblätter sind weißlich mit violett-blauen Adern. Zur Hauptblütezeit im Juni erscheinen Wiesen mit Sibirischer Schwertlilie in einem strahlenden Blauviolett. Im nicht-blühenden Zustand wirkt die Art mit ihren nur 2 bis 6 mm breiten Blättern wie ein Gras.
Verbreitung
Die Sibirische Schwertlilie ist von Mitteleuropa bis in die Mongolei verbreitet. In Österreich kommt sie in allen Bundesländern vor.
Gefährdung und Schutz
Die Art wird in der Roten Liste Österreichs als gefährdet („Vulnerable“) eingestuft, da sie nur zerstreut verbreitet ist, ein massiver Rückgang des Bestands zu beobachten ist und das Risiko eines weiteren Rückgangs besteht. Innerhalb Österreichs bestehen regional unterschiedliche Einstufungen der Gefährdung, im Pannonikum gilt die Sibirische Schwertlilie zum Beispiel als stark gefährdet. Die primäre Gefährdungsursache ist der Lebensraumverlust durch Drainage und Düngung von Feuchtlebensräumen in Kombination mit der zunehmenden Konkurrenz durch invasive Pflanzenarten. Botanische Gärten können durch Ex-situ-Kulturen zum Erhalt der Art beitragen und durch Wiederauspflanzung das Überleben der Populationen vor Ort unterstützen.
Besonderheiten
Die Sibirische Schwertlilie ist eine der vielen seltenen und attraktiven Blütenpflanzen der Pfeifengraswiesen, die früher als Streuwiesen genutzt wurden und die inzwischen fast gänzlich aus unseren Landschaften verschwunden sind. Diese wenig rentablen, da schwierig zu bewirtschaftenden Standorte sind größtenteils verlorengegangen und mit ihnen die Artenvielfalt dieser ehemals bunten Wiesen. Die Sibirische Schwertlilie findet auch in der Gartenkultur Verwendung. Es gibt zahlreiche Sorten, die sich in Höhe und Blütenfarbe unterscheiden. Kultiviert werden oft auch Hybriden mit Iris sanguinea.
Kleines Mädesüß Filipendula vulgaris – Rosaceae

Das Kleine Mädesüß gehört zur Familie der Rosengewächse. Im Gegensatz zum nah verwandten Großen Mädesüß kommt es nicht auf feuchten Standorten vor und duftet weit weniger intensiv.
Aussehen und Standortansprüche
Das Kleine Mädesüß wird bis zu 80 cm hoch. Die kleinen milchweißen Blüten erscheinen zwischen Juni und August und sind außen oft rötlich überlaufen. Die auffällig strahlig ausgebreiteten Griffel laden Bestäuber dazu ein, sich niederzulassen. Auch Selbstbestäubung ist möglich. Hierbei krümmen sich die inneren Staubblätter zur Narbe hin und bestäuben den Griffel. Die Samen besitzen an der Spitze einen kleinen Haken (Griffelrest) und sind behaart. Diese Eigenschaften der “Hakelfrucht” fördern die Ausbreitung der Samen, die sich wie eine Klette an Fell oder Gewand heften. Das Kleine Mädesüß findet man auf nährstoffarmen Wiesen, lichten Wäldern und an Gebüschsäumen.
Verbreitung
In Österreich kommt das Kleine Mädesüß im Tief- und Hügelland vor (ausgenommen Vorarlberg). Ihre eurasiatische Verbreitung reicht von den Azoren über das nordwestliche Afrika bis ins südliche Sibirien und den Iran.
Gefährdung und Schutz
Die Rote Liste Österreichs stuft die Art als gefährdet („Vulnerable“) ein. Die kleinen, isolierten Vorkommen sind oft durch zu frühe Schnittzeitpunkte, Eutrophierung oder Intensivierung im Rückgang betroffen. Erfreulicherweise können sich einzelne Populationen durch gezieltes Management wieder erholen.
Besonderheiten
Der botanische Name der Gattung Filipendula setzt sich aus dem lateinischen Namen für lat. Filum (= Faden), und pendulus (= hängend) zusammen, was auf die verdickten Wurzeln zurückzuführen ist. Für Wildgärten wird diese sehr attraktive heimische Staude oft empfohlen.
Bildergalerie
Sammeln
Vermehren
Wiederansiedeln
Dokumentieren
Positionspapier Botanischer Artenschutz
Der Verband Botanischer Gärten e.V. (VBG) ist der Dachverband Botanischer Gärten im deutschsprachigen Raum. Seine Mitglieder arbeiten eng in zahlreichen aktiven Arbeitsgruppen zusammen. Als starkes, professionelles Netzwerk setzt er sich für den Erhalt der biologischen Vielfalt ein und orientiert sich dabei an den Zielen der nachhaltigen Entwicklung der Vereinten Nationen und an den Zielen der internationalen Biodiversitätskonvention (CBD).
Ausgangslage
In Deutschland, Österreich und der Schweiz sind rund ein Drittel aller natürlich vorkommenden Farn- und Blütenpflanzenarten gefährdet oder ausgestorben, und mit ihnen auch die Lebensgrundlage für andere Arten. Die Umsetzung der erklärten Ziele der UN-Dekade für Wiederherstellung der Natur, des Kunming-Montreal Global Biodiversity Framework (GBF), sowie der EU-Wiederherstellungs-Verordnung (WVO) und der Nationalen Strategie zur Biologischen Vielfalt 2030 (NBS) ist eine der dringendsten Herausforderungen unserer Zeit.
Botanische Gärten sind Schlüsselakteure im Artenschutz
Botanische Gärten sammeln, kultivieren, vermehren und erforschen seit Jahrhunderten Wildpflanzen aus aller Welt. In den letzten Jahrzehnten widmen sich die meist universitären Einrichtungen zunehmend der Erhaltung und Förderung der einheimischen Pflanzenwelt und sind mit ihrer wissenschaftlichen und gärtnerischen Expertise ein wichtiges Bindeglied zwischen Forschung sowie behördlichem und ehrenamtlichem Naturschutz geworden. Als Orte der Bildung, des Wohlfühlens und der aktiven Erholung tragen sie zudem naturwissenschaftliche Erkenntnisse in die breite Öffentlichkeit.
Zentrale Handlungsfelder im botanischen Artenschutz
Umsetzung von Erhaltungs- und Förderungsmaßnahmen
In ihrer täglichen Arbeit wenden Botanische Gärten regelmäßig erprobte und umsetzungsreife Strategien an und entwickeln diese weiter, um zur Erhaltung und Förderung unserer Pflanzenvielfalt beizutragen. Sie arbeiten dafür gemeinsam mit dem behördlichen und ehrenamtlichen Naturschutz. Botanische Gärten sichern gefährdete Wildpflanzen in ihren Saatgutbanken und pflegen und vermehren sie in Erhaltungskulturen. Über die Ansiedlung in natürliche und renaturierte Lebensräume fördern Botanische Gärten die Bestände gefährdeter Pflanzenarten und verhindern ihr Aussterben.
Gesellschaftliche Bildung
Botanische Gärten sind ein wichtiges Sprachrohr für die Belange des Naturschutzes im Allgemeinen und des botanischen Artenschutzes im Speziellen. Sie sind Schaufenster und Bildungseinrichtung. Jährlich werden sie von ca. 14 Mio. Gästen im deutschsprachigen Raum besucht. Im Sinne des Leitbilds der „Bildung für nachhaltige Entwicklung“ fungieren Botanische Gärten als bedeutsame außerschulische Lernorte, die ein breites Spektrum an Bildungsformaten für Zielgruppen sämtlicher Altersstufen bereitstellen. Damit sind sie wichtige Orte, um die Gesellschaft für die Bedeutung pflanzlicher Vielfalt als Grundlage unseres Lebens auf der Erde zu sensibilisieren.
Gärtnerische Kompetenzen
Hoch qualifizierte Gärtnerinnen und Gärtner in den Botanischen Gärten versorgen ihre Pflanzen täglich und bei jedem Wetter. Bei der Anzucht und Kultur von gefährdeten einheimischen Wildpflanzen ist besondere gärtnerische Expertise vonnöten; der Optimierung der herausfordernden artspezifischen Kulturbedingungen stellen sich die Kolleginnen und Kollegen mit Experimentierfreude und Frustrationstoleranz.
Wichtig für die tägliche Arbeit ist der länderübergreifende fachliche Austausch in den VBG-Arbeitsgruppen, wie z. B. in der AG Botanischer Artenschutz. Darüber hinaus werden diese Kompetenzen und die damit verbundenen wissenschaftlichen Grundlagen über den einzigartigen Qualifizierungskurs des VBG “Gärtner*in im Botanischen Artenschutz” weitergegeben.
Forschung
Botanische Gärten mit Bindung an Universitäten arbeiten in überregionalen, internationalen und interdisziplinären Forschungsnetzwerken. Sie vereinen somit wissenschaftliche und gärtnerische Expertisen, die eine unverzichtbare Basis für die oft sehr aufwändige und herausfordernde Kultivierung und Vermehrung bedrohter Pflanzenarten sind. Wissenschaftlerinnen und Wissenschaftler des Verbandes erforschen populationsgenetische und keimungsbiologische Grundlagen und untersuchen Methoden von Translokationen und Wiederansiedlungen. Als unabhängige Spezialistinnen und Spezialisten entwickeln sie gemeinsam mit weiteren wichtigen Akteuren Strategien und Konzepte für den botanischen Artenschutz.
Vision und Mission
Zukünftige Generationen sollen vielfältige Lebensräume und funktionierende Ökosysteme erleben können. Die botanische Vielfalt ist hierfür eine wesentliche Grundlage. Nur durch eine integrative Herangehensweise, die Wissenschaft, Politik und Gesellschaft verbindet, kann die Biodiversität langfristig gesichert werden.
Als Schlüsselakteure sind Botanische Gärten erste Ansprechpartner für die Förderung und Sicherung seltener und gefährdeter Pflanzenarten. Sie können und wollen verstärkt Verantwortung für die Artenvielfalt übernehmen. Ihre multidimensionale Arbeit – von der Arterhaltung bis zur Bildung – muss gestärkt werden, um die verpflichtenden Ziele der UN-Dekade für Wiederherstellung und des Global Biodiversity Framework zu erreichen. Dazu braucht es die Bereitschaft politischer Akteure, Botanische Gärten mit ihrer Kompetenz und Expertise für diese speziellen Aufgaben finanziell auszustatten.
Der Verband Botanischer Gärten bietet an, im Austausch mit Verantwortlichen aus Politik, Wirtschaft, Verwaltung und Interessenverbänden nachhaltige Lösungen zu finden und in der Umsetzung mitzuwirken.